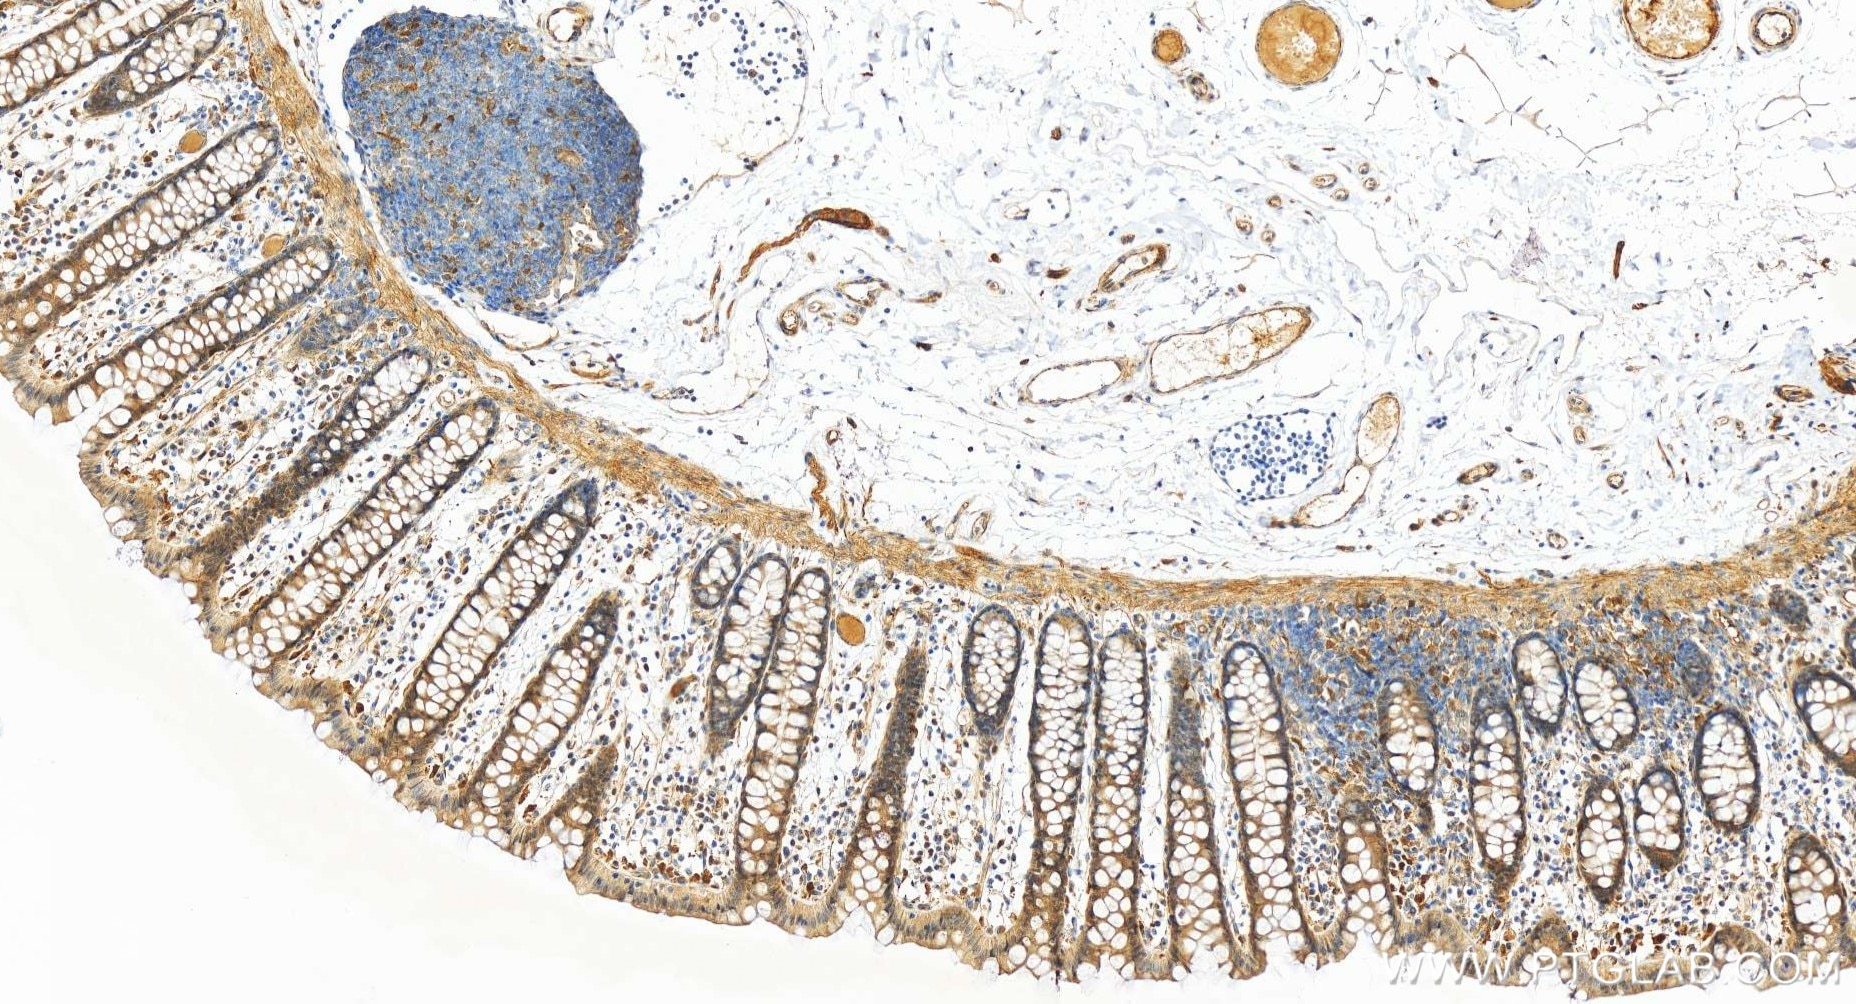
Immunohistochemistry (IHC) staining of human colon tissue using TIGAR Recombinant antibody (85052-4-RR)
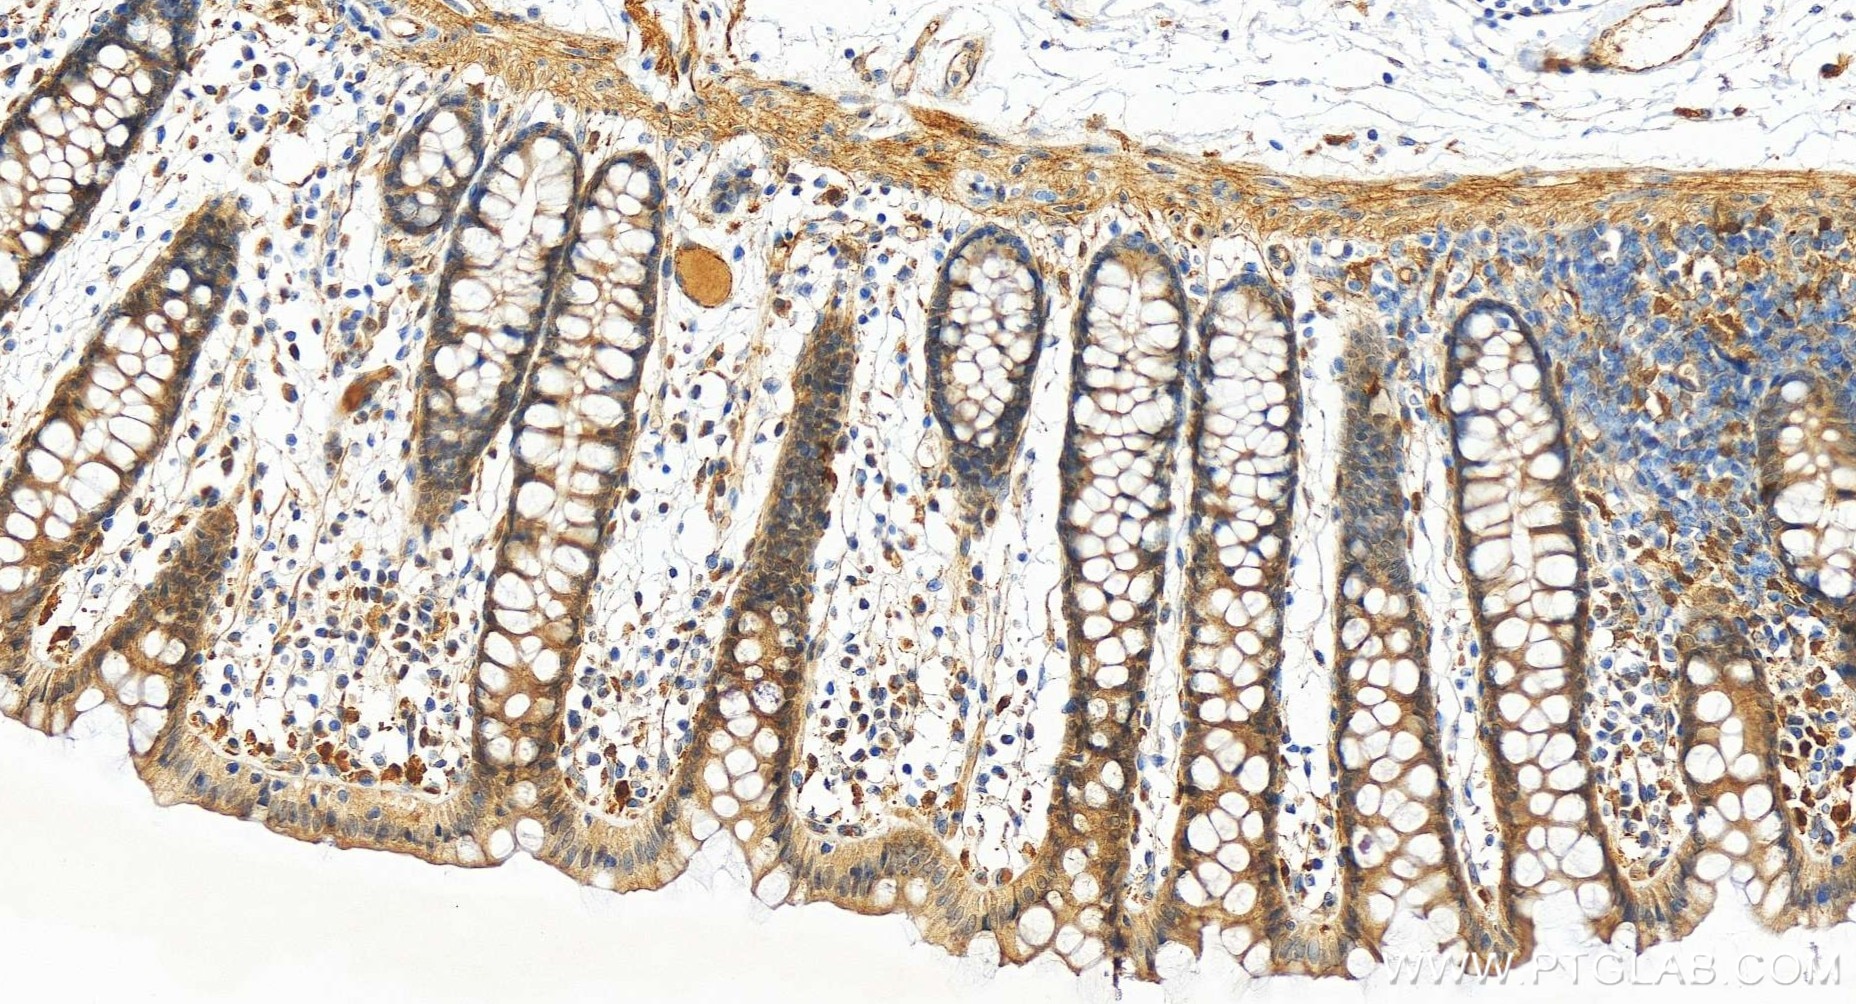
Immunohistochemistry (IHC) staining of human colon tissue using TIGAR Recombinant antibody (85052-4-RR)

Tested Applications
| Positive WB detected in | MCF-7 cells, HEK-293 cells, HCT 116 cells, Jurkta cells, HeLa cells |
| Positive IHC detected in | human colon tissue Note: suggested antigen retrieval with TE buffer pH 9.0; (*) Alternatively, antigen retrieval may be performed with citrate buffer pH 6.0 |
Recommended dilution
| Application | Dilution |
|---|---|
| Western Blot (WB) | WB : 1:2000-1:10000 |
| Immunohistochemistry (IHC) | IHC : 1:250-1:1000 |
| It is recommended that this reagent should be titrated in each testing system to obtain optimal results. | |
| Sample-dependent, Check data in validation data gallery. | |
Product Information
85052-4-RR targets TIGAR in WB, IHC, ELISA applications and shows reactivity with human samples.
| Tested Reactivity | human |
| Host / Isotype | Rabbit / IgG |
| Class | Recombinant |
| Type | Antibody |
| Immunogen |
CatNo: Ag17532 Product name: Recombinant human TIGAR protein Source: e coli.-derived, PGEX-4T Tag: GST Domain: 1-270 aa of BC012340 Sequence: MARFALTVVRHGETRFNKEKIIQGQGVDEPLSETGFKQAAAAGIFLNNVKFTHAFSSDLMRTKQTMHGILERSKFCKDMTVKYDSRLRERKYGVVEGKALSELRAMAKAAREECPVFTPPGGETLDQVKMRGIDFFEFLCQLILKEADQKEQFSQGSPSNCLETSLAEIFPLGKNHSSKVNSDSGIPGLAASVLVVSHGAYMRSLFDYFLTDLKCSLPATLSRSELMSVTPNTGMSLFIINFEEGREVKPTVQCICMNLQDHLNGLTETR Predict reactive species |
| Full Name | chromosome 12 open reading frame 5 |
| Calculated Molecular Weight | 270 aa, 30 kDa |
| Observed Molecular Weight | 30 kDa |
| GenBank Accession Number | BC012340 |
| Gene Symbol | TIGAR |
| Gene ID (NCBI) | 57103 |
| Conjugate | Unconjugated |
| Form | Liquid |
| Purification Method | Protein A purification |
| UNIPROT ID | Q9NQ88 |
| Storage Buffer | PBS with 0.02% sodium azide and 50% glycerol, pH 7.3. |
| Storage Conditions | Store at -20°C. Stable for one year after shipment. Aliquoting is unnecessary for -20oC storage. 20ul sizes contain 0.1% BSA. |
Background Information
The TP53-induced glycolysis and apoptosis regulator (TIGAR), first reported in 2006, is a downstream target gene of p53 and an important factor involved in glycolysis and apoptosis . It is indispensable in metabolism and is involved in metabolic syndrome, including hyperglycemia, insulin resistance, alcoholic fatty liver and tissue ischemia. TIGAR is highly expressed in many cancer cells to promote cell survival.
Protocols
| Product Specific Protocols | |
|---|---|
| IHC protocol for TIGAR antibody 85052-4-RR | Download protocol |
| WB protocol for TIGAR antibody 85052-4-RR | Download protocol |
| Standard Protocols | |
|---|---|
| Click here to view our Standard Protocols |